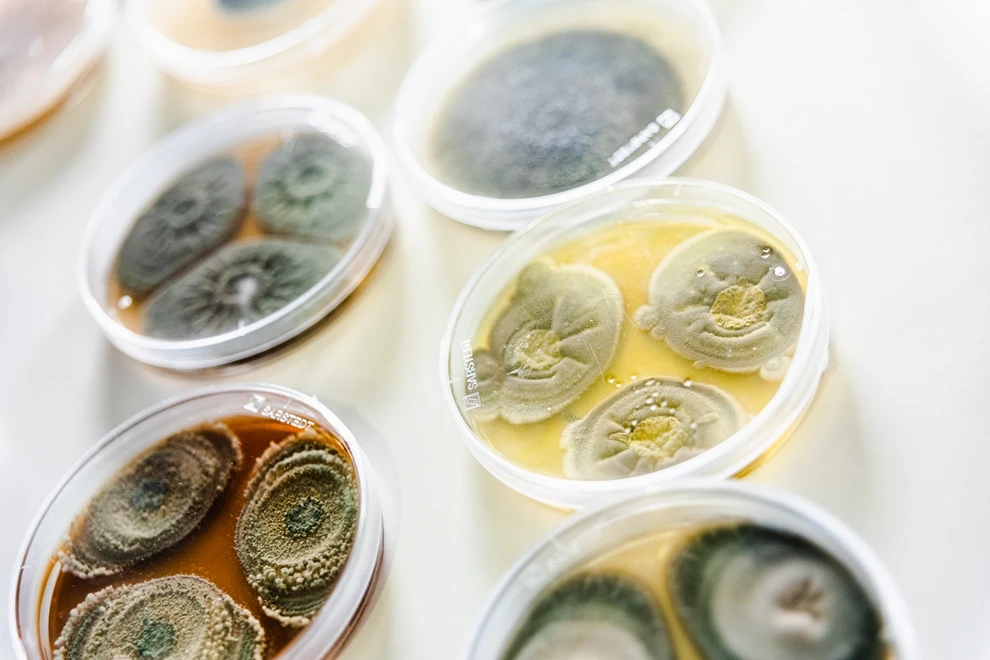

Η μούχλα που βρέθηκε στον χώρο της πυρηνικής καταστροφής του Τσερνόμπιλ φαίνεται ότι τρέφεται από την ακτινοβολία. Μπορεί να χρησιμοποιηθεί για την προστασία των αστροναυτών από τις κοσμικές ακτίνες;
Τον Μάιο του 1997, η Νέλι Ζντάνοβα εισήλθε σε έναν από τους πιο ραδιενεργούς τόπους της Γης, τα εγκαταλελειμμένα ερείπια του εκραγέντος πυρηνικού εργοστασίου του Τσερνόμπιλ και διαπίστωσε ότι δεν ήταν μόνη. Στο ταβάνι, στους τοίχους και μέσα σε μεταλλικούς αγωγούς που προστατεύουν τα ηλεκτρικά καλώδια, η μαύρη μούχλα είχε εγκατασταθεί σε έναν χώρο που κάποτε θεωρούνταν εχθρικός για τη ζωή.
Στα χωράφια και τα δάση γύρω από το εργοστάσιο, λύκοι και αγριογούρουνα είχαν ανακάμψει απουσία ανθρώπων. Ακόμη και σήμερα υπάρχουν περιοχές με εξαιρετικά υψηλά επίπεδα ακτινοβολίας, λόγω υλικών που εκτοξεύθηκαν από τον αντιδραστήρα κατά την έκρηξη.
Η μούχλα, που αποτελείτο από διάφορα είδη μυκήτων, έδειχνε κάτι αξιοσημείωτο. Δεν είχε απλώς εισβάλει επειδή οι εργαζόμενοι είχαν φύγει. Η Ζντάνοβα είχε βρει σε προηγούμενες έρευνες ότι οι μύκητες αναπτύσσονταν προς τα ραδιενεργά σωματίδια που καλύπτουν την περιοχή. Τώρα, διαπίστωσε ότι είχαν φτάσει στους χώρους μέσα στο κτίριο του αντιδραστήρα, την αρχική πηγή της ακτινοβολίας.
Κάθε έρευνα που την έφερνε κοντά σε επικίνδυνη ακτινοβολία, ανέτρεπε τις μέχρι τότε αντιλήψεις για το πώς επηρεάζει τη ζωή στη Γη. Η ανακάλυψή της προσφέρει πλέον ελπίδα για καθαρισμό ραδιενεργών περιοχών και ίσως τρόπους προστασίας των αστροναυτών κατά τα ταξίδια τους στο διάστημα, σύμφωνα με το BBC.
Έντεκα χρόνια πριν από την επίσκεψη της Ζντάνοβα, ένας τακτικός έλεγχος ασφαλείας του αντιδραστήρα τέσσερα στο πυρηνικό εργοστάσιο του Τσερνόμπιλ μετατράπηκε στη χειρότερη πυρηνική καταστροφή του κόσμου. Μια σειρά σφαλμάτων στον σχεδιασμό και τη λειτουργία του οδήγησε σε μια τεράστια έκρηξη στις πρώτες ώρες της 26ης Απριλίου 1986, απελευθερώνοντας μια μεγάλη ποσότητα ραδιονουκλεϊδίων. Το ραδιενεργό ιώδιο αποτέλεσε βασική αιτία θανάτου τις πρώτες μέρες και εβδομάδες και αργότερα, καρκίνου.
Για να μειωθεί ο κίνδυνος δηλητηρίασης από ακτινοβολία και μακροπρόθεσμων προβλημάτων υγείας, δημιουργήθηκε μια ζώνη αποκλεισμού 30 χλμ (γνωστή και ως «ζώνη αλλοτρίωσης») για να κρατηθούν οι άνθρωποι μακριά από τα πιο επικίνδυνα σημεία του αντιδραστήρα τέσσερα.
Ενώ οι άνθρωποι παρέμεναν μακριά, η μαύρη μούχλα της Ζντάνοβα αποίκισε αργά την περιοχή. Όπως τα φυτά που απλώνουν τα φύλλα τους προς το φως, οι υφές της μούχλας φαινόταν να προσελκύονται από την ιονίζουσα ακτινοβολία. Αυτή η διαδικασία, που η Ζντάνοβα ονόμασε «ακτινοτροπισμό», ήταν παράδοξη: η ιονίζουσα ακτινοβολία είναι πολύ πιο ισχυρή από το ηλιακό φως, προκαλώντας βλάβες στο DNA και στις πρωτεΐνες, οι οποίες μπορεί να οδηγήσουν σε θάνατο των οργανισμών.
Μαζί με τους ακτινοτροπικούς μύκητες, η Ζντάνοβα εντόπισε ακόμη 36 είδη κοινών μυκήτων γύρω από το Τσερνόμπιλ. Στις επόμενες δύο δεκαετίες, το πρωτοποριακό της έργο επεκτάθηκε πέρα από την Ουκρανία, προσφέροντας νέα γνώση για μια πιθανή μορφή ζωής που ανθεί με ακτινοβολία αντί για φως, οδηγώντας τη NASA να εξετάσει τη χρήση μυκήτων για την προστασία των αστροναυτών.
Στο επίκεντρο αυτής της ιστορίας βρίσκεται η μελανίνη, ένα μόριο ευρέως διαδεδομένο στη ζωή στη Γη. Η μελανίνη, που κυμαίνεται από μαύρη έως κοκκινοκαφέ, καθορίζει τα διαφορετικά χρώματα δέρματος και μαλλιών στους ανθρώπους. Είναι επίσης η αιτία που οι μύκητες στο Τσερνόμπιλ ήταν μαύροι, καθώς τα κυτταρικά τους τοιχώματα ήταν γεμάτα με μελανίνη.
Όπως το σκοτεινό δέρμα προστατεύει τα κύτταρα από την υπεριώδη ακτινοβολία, η Ζντάνοβα υπέθεσε ότι η μελανίνη των μυκήτων λειτουργεί ως ασπίδα κατά της ιονίζουσας ακτινοβολίας. Το ίδιο παρατηρήθηκε και σε βατράχια γύρω από το Τσερνόμπιλ, όπου τα πιο σκούρα άτομα με μεγαλύτερη μελανίνη επιβίωναν καλύτερα και αναπαράγονταν, οδηγώντας σε μαύρη πληθυσμιακή μετατόπιση.
Η μελανίνη δεν λειτουργεί όπως μια φυσική ασπίδα που απλώς αποκρούει ένα βέλος. Η ακτινοβολία απορροφάται από τη δομή της και η ενέργειά της διαχέεται. Η μελανίνη είναι επίσης αντιοξειδωτικό μόριο που επαναφέρει τα αντιδραστικά ιόντα σε σταθερή κατάσταση.
Το 2007, η Εκατερίνα Νταδάκοβα, πυρηνική επιστήμονας στο Albert Einstein College of Medicine στη Νέα Υόρκη, συνέβαλε στην έρευνα της Ζντάνοβα, αποκαλύπτοντας ότι η ανάπτυξη των μελανωμένων μυκήτων αυξανόταν παρουσία ακτινοβολίας. Οι μύκητες που καλλιεργήθηκαν με ραδιενεργό καίσιο αναπτύχθηκαν 10% πιο γρήγορα από τους ίδιους που καλλιεργήθηκαν χωρίς ακτινοβολία. Ο Νταδάκοβα και η ομάδα της διαπίστωσαν ότι οι μύκητες χρησιμοποιούσαν την ενέργεια της ακτινοβολίας για να ενισχύσουν τον μεταβολισμό τους, μια διαδικασία που ονόμασαν «ραδιοσύνθεση».
Η ραδιοσύνθεση βασίζεται στη μελανίνη, η οποία μετατρέπει την ιονίζουσα ακτινοβολία σε ενέργεια χρήσιμη για ανάπτυξη. Αν και ακόμα θεωρητική, η διαδικασία απαιτεί τον προσδιορισμό του μηχανισμού με τον οποίο η μελανίνη επηρεάζει τον μεταβολισμό των μυκήτων.
Δεν εμφανίζουν όλοι οι μελανωμένοι μύκητες ακτινοτροπισμό ή θετική ανάπτυξη σε ακτινοβολία. Σε μια μελέτη του 2006, μόνο 9 από τα 47 είδη μυκήτων που συλλέχθηκαν στο Τσερνόμπιλ μεγάλωσαν προς την πηγή ραδιενεργού καίσιου. Αντίστοιχα, το 2022, ερευνητές στο Sandia National Laboratories στο Νέο Μεξικό δεν παρατήρησαν διαφορά ανάπτυξης όταν δύο είδη μυκήτων εκτέθηκαν σε UV ακτινοβολία και καίσιο-137.
Ωστόσο, η τάση για αύξηση της ανάπτυξης όταν οι μύκητες εκτίθενται σε ακτινοβολία επανεμφανίστηκε στο διάστημα. Η γαλαξιακή κοσμική ακτινοβολία, προερχόμενη από εκρήξεις άστρων έξω από το ηλιακό σύστημα, αποτελεί αόρατη καταιγίδα φορτισμένων πρωτονίων που διαπερνά ακόμη και το μόλυβδο. Στη Γη, η ατμόσφαιρα μας προστατεύει, αλλά για αστροναύτες σε αποστολές βαθιάς διαστήματος είναι ο μεγαλύτερος κίνδυνος για την υγεία τους.
Δείγματα του μύκητα Cladosporium sphaerospermum, που η Ζντάνοβα είχε βρει στο Τσερνόμπιλ, στάλθηκαν στον Διεθνή Διαστημικό Σταθμό τον Δεκέμβριο του 2018. Οι ερευνητές, μεταξύ αυτών ο Νιλς Άβερες από το Πανεπιστήμιο της Φλόριντα, διαπίστωσαν ότι οι μύκητες αναπτύσσονταν 1,21 φορές πιο γρήγορα από ό,τι στη Γη.
Επιπλέον, η μελανίνη των μυκήτων φάνηκε να λειτουργεί ως προστατευτικό φράγμα, μειώνοντας την ακτινοβολία για τους αισθητήρες κάτω από τα δείγματα. Αν και δεν αποκλείεται η προστατευτική επίδραση να οφείλεται και σε άλλους βιολογικούς παράγοντες, τα ευρήματα ανοίγουν νέες προοπτικές για την προστασία των ανθρώπων σε βάσεις σε Σελήνη και Άρη.
Η «μυκο-αρχιτεκτονική», δηλαδή η χρήση μυκήτων για την κατασκευή επίπλων και τοιχών σε βάσεις στο διάστημα, θα μπορούσε να μειώσει το κόστος μεταφοράς υλικών και να προσφέρει μια αναγεννώμενη ασπίδα κατά της κοσμικής ακτινοβολίας. Όπως οι μαύροι μύκητες αποίκισαν έναν εγκαταλελειμμένο κόσμο στο Τσερνόμπιλ, ίσως μια μέρα να προστατεύσουν και τα πρώτα βήματα της ανθρωπότητας σε νέους κόσμους στο Ηλιακό Σύστημα.